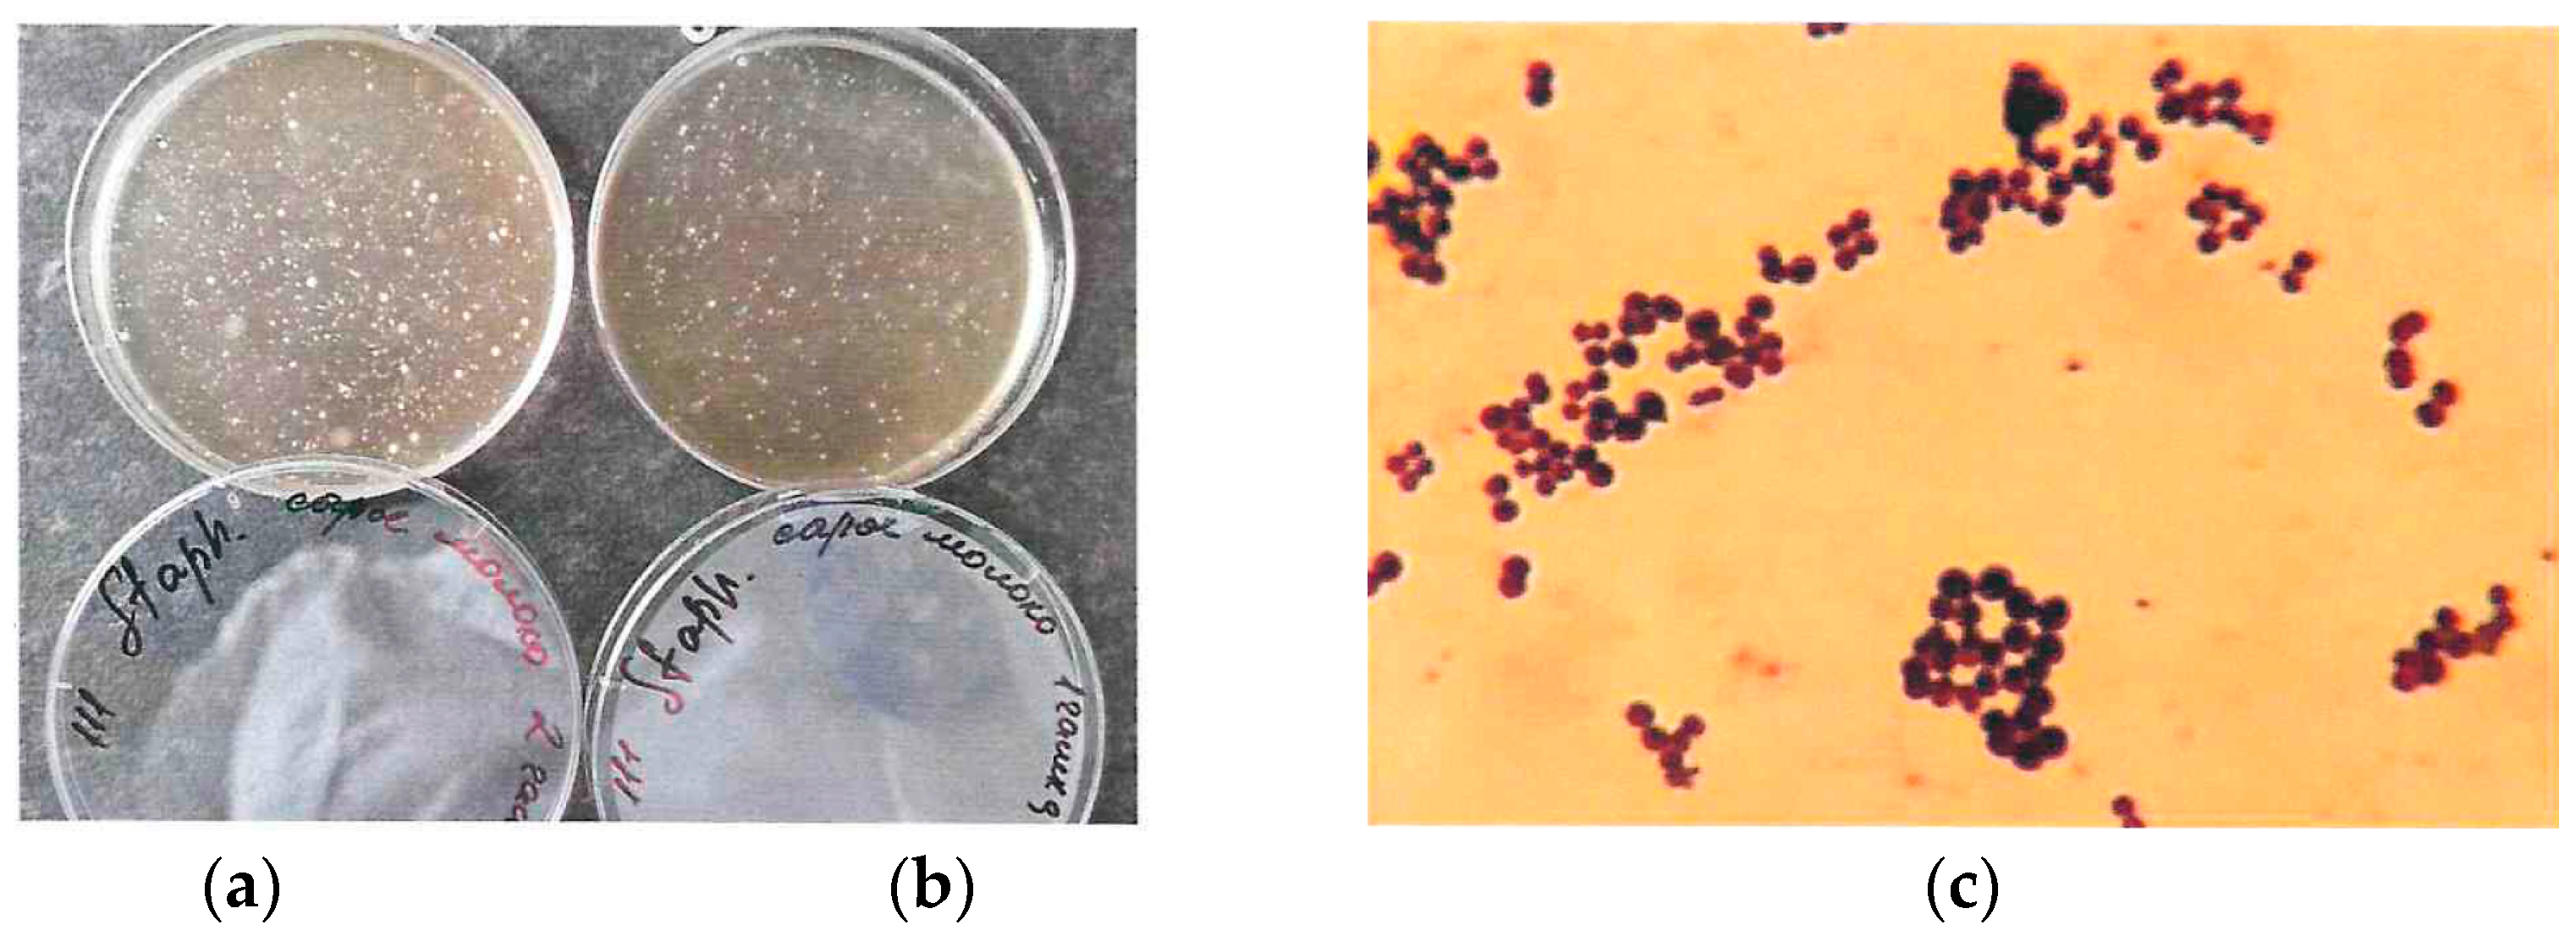
Applsci 13 11836 g003

Abstract
Contamination of the inner surface of milk hoses of milking systems with milk residues, water residues and pathogenic microflora has a negative impact on milk quality and can affect the accuracy of light-scattering sensors measuring milk quality parameters. A three-stage study of the influence of milking system operating conditions on the accuracy of a light-scattering sensor is presented. The growth of pathogenic microflora on the inner surface of milk hoses was studied, the flow of milk and milk hoses rinsing was simulated and the accuracy of the light-scattering sensor was tested under conditions of low-quality rinsing of the milking system. A significant difference in the total microbial count was detected between the milk residues of healthy animals and the milk residues of animals with subclinical mastitis (1.2 × 104 CFU/mL and 9.2 × 104 CFU/mL). The presence of Staphylococcus (aureus and epidermidis) was detected in quantities much lower than those that could interfere with the analysis of milk quality parameters. Simulation modeling allowed us to prove that even when rinsing with hot water (80 °C) without chemical solutions, pathogenic microflora in milk hoses of the milking system will be suppressed. Modeling of the milk flow in the measuring chamber of the device showed the stable replacement of milk in the measuring chamber and provided actual measurements of milk quality parameters. It has been determined that low-quality rinsing and water residues in milk hoses lead to a significant increase in measurement error up to 15–20% during the first 30–40 s after the milking system starts operating. The study results confirm that the light-scattering sensors are resistant to such factors of the milking system operation as contamination by pathogenic microflora (S. aureus and S. epidermidis) and low-quality rinsing of milk hoses.
1. Introduction
Maintaining milking equipment in a clean and serviceable condition by treating the working surfaces of the equipment with cleaning and antimicrobial agents is necessary for the production of high-quality milk. However, the actual maintenance of the equipment does not always meet these standards. It is also unknown what effects contaminated working surfaces of the equipment have on the performance of milk quality control devices. For inline milk quality control devices, integrated into milk hoses, optical diagnostic methods are the most promising, since these methods allow the performance of non-contact and non-destructive diagnostics with high sensitivity and speed [1,2,3,4,5]. Thus, a device for analyzing the milk quality must contain an optical unit for diagnosing the medium being tested, which is milk. During milking system operation, milk should not be contaminated with any objects affecting its optical properties. For example, water entering the milk hoses disrupts the milk flow proportions. Keeping the internal surfaces of the milking system clean is necessary to ensure this condition.
Milking systems provide a favorable environment for the growth of pathogenic microflora (including S. aureus and S. epidermidis), which can cause significant damage to animal health and milk quality. Effective udder hygiene before milking is essential for the production of high-quality milk [6]. Jing Zhang et al. conducted an extensive study on the prevalence and antimicrobial resistance of S. aureus [7]. Milk contaminated with S. aureus causes poisoning and acute gastroenteritis, affecting food safety and human health. Reliable antimicrobial cleaning of milking equipment requires knowledge of the minimum number of organisms that can cause udder infections such as mastitis. It is necessary to know which animals are sources of infection in herds and transmit infection to lactating and non-lactating cows [8]. Bovine mastitis is dangerous because of its effect on the quantity and quality of milk yield [9]. For example, Staphylococcus aureus strains, which are insensitive to many antibiotics, are currently considered the most dangerous causative agents of bovine mastitis [10]. About 60–70% of all antimicrobials used on dairy farms are used for the prevention and treatment of mastitis [11]. The common feature of all pathogenic cocci is their ability to cause purulent processes, so they are called pus-producing (pyogenic). Staphylococcus aureus is the least demanding to media and biochemically more active than other cocci.
Staphylococcus are round spheres of 0.5–1.5 µm in diameter (while the average size of milk fat globules in cows’ milk is 3.5 µm). They grow and multiply on ordinary nutrient media and grow well on media with blood or milk, with optimal conditions of temperature of 37 °C and a pH of the environment of 7.2–7.4. (pH of milk—6.6–6.8). When they grow, Staphylococcus form a pigment: golden, lemon-yellow or white. The pigment is best formed on milk medium at room temperature and under diffused light. The presence of this pigment can influence the light-scattering phenomenon in milk. At 100 °C, Staphylococcus die instantly, at 70 °C—in 10–15 min, so if hoses rinsed with hot water, pathogens will last at least for a period of 10–15 min and then ultimately die. There is a microbial resistance passport for a dairy farm describing the core of the opportunistic microbiocenosis (Ent. faecium, Ent. faecalis, S. aureus, S. epidermidis, S. saprophyticus, P. aeruginosa, P. vulgaris, P. mirabilis, Echerichia coli, Aspergillus spp. and C. Albicans), occurring in more than 15% of cases [12,13]. Studies show that pathogens can be isolated from a small but significant percentage of raw milk produced even under hygienic conditions [14].
The contamination of milk with pathogenic microflora can occur in several ways. In addition to infected animals and undisinfected teat cups, there is the problem of pathogen colonies sticking to biofilms on stainless steel, rubber and plastic [15]. Biofilms are bacteria which are able to attach to the surfaces of equipment. Stainless steel has strong adhesion to biofilms and is easy to clean. Silicon is less susceptible to biofilms, but cleaning parameters and resistance to solvents can vary significantly between formulations. PVC is a milk hose material with similar properties to rubber. Glass is practically immune to biofilm adhesion, is easy to clean and is resistant to concentrated washing solutions. The roughness of the glass is very small, which contributes to resistance to adhesion and allows easy rinsing. Colonies of pathogenic microflora can adhere to biofilms formed on the inner surfaces of metal, plastic and rubber surfaces. One study showed that plastic is easier to maintain in an acceptable condition than rubber [16]. Numerous bacteria are able to attach to the surfaces of equipment used for food processing or handling; for example, Enterococcus durans strain is a biofilms producer at 25, 30 or 37 °C on polystyrene microtiter plates. En. durans and cell-free culture supernatant showed a significant (p < 0.05) pathogen inhibitory potential on both solid media and broth co-cultures. Dairy biofilms as a source of contamination for milk and dairy products are of great concern in the dairy industry [17]. The presence of biofilms has been demonstrated on several materials including stainless steel and plastic, which are often used in milking machines as well as in milk processing plants, with mainly Gram-positive bacteria growing. PVC hoses account for about 80% of the total inner surface area of milking systems (from the teat cups to the milk pipe), so we considered this material when studying pathogenic microflora growth on the inner surfaces of milking systems.
Udder sanitation practices can vary considerably from farm to farm. Some use probiotics to reduce the amount of opportunistic microflora (Staphylococcus aureus, Esherichia coli) [18]. The main sources of contamination include animal feces, dirt from teats, udders and tails; bacteria due to improper milking practices, dirty hands, insufficiently cleaned and disinfected equipment (including milk tanks), and a lack of teat cleaning and disinfection before milking; foreign bodies, especially from dead components of the milking unit and filling tanks, dust, bedding materials, manure, insects and animal hair; chemicals, metals, organic matter, etc., from residues of veterinary drugs, cleaning chemicals and the use of non-food equipment [19]. In Germany, the spray method of preventive intermediate disinfection of the milking machine is often used [20].
In addition, the inner surfaces of milk hoses are contaminated by milk residues and water residues from low-quality hoses. Low-quality rinsing of milk hoses leads to the adhesion of dirt, which reduces the quality of milk and possibly affects the accuracy of optical/light-scattering sensors and may lead to the inability to detect abnormal milk (increased concentration of somatic cell count (SCC)). For practical application of light-scattering sensors on a dairy farm, it is necessary to study the hygiene parameters of the inner surface of the milk hose 30–50 cm from the teat cups, as well as in the measuring chamber of the device, which has a complex shape with a trough for milk drainage. The buildup of objects with a diameter of 1–1.5 µm and larger, possessing white pigment and having a spherical shape can affect the accuracy of light-scattering sensors integrated into milking systems (measuring fat globules of 3–3.5 µm and individual milk fat molecules of 0.5–2 µm).
The study of the influence of operating conditions on the accuracy of light-scattering sensors integrated into milking systems set the following aims:
- -
- to study the growth of pathogenic microflora (including S. aureus and S. epidermidis) on the inner surfaces of PVC hoses of the milking system;
- -
- to develop a simulation model of the milk flow and rinsing liquid in the measuring chamber of the light-scattering sensor to study the influence of the measuring chamber shape on the milk flow;
- -
- to test the accuracy of the light-scattering sensor and evaluate the effect of milking system operating conditions on the accuracy of the light-scattering sensor.
2. Materials and Methods
2.1. Description of the Dairy Farm, Milk and Milk Hoses Used in the Study
We used the study object milk from a commercial farm located in Central Russia, Moscow region. All animals belonged to the black-brown Holsteinized breed of dairy cows. On the farm, milking is twofold, between 5 a.m. and 8 a.m. and 4 p.m. and 7 p.m. There is an eight-hour interval between milkings for every animal. The main herd of healthy animals is milked with the Herringbone milking machine 2 × 12. Animals with subclinical mastitis are milked with the Herringbone milking system 2 × 4. Before milking, the asepsis prevention rules were observed—udder teats were wiped with a cotton swab moistened with 70° antiseptic. To ensure milk safety and the absence of contamination factors, a complete rinsing of the milking machine was carried out: combined washing of the milking machine with an alkaline agent, then an acidic agent with double rinsing. The temperature of the rinsing liquid was 80–85 °C, the liquid volume was 100 L, the total rinsing time was 600 s and the solution had a concentration of 0.5%. The milk hose drying time was 120 s.
In this study, we used milk from healthy animals and animals with subclinical mastitis. Milk was collected in sterile containers after morning milking. In total, 30 L of milk with a 3.83% fat content and 30 L of milk with a 4.31% fat content from healthy animals were used for the study; 2 L of milk with a 4.33% fat content from animals with subclinical mastitis was used (the milk fat content was checked with a reference device—Laktan 1–4 M (Sibagrodevice, Russia)). The diagnosis of subclinical mastitis was confirmed using Kenotest, manufactured by CID Lines NV, Belgium. The assessment of somatic cell count (SCC) was performed as follows: Step 1—the first three streams of milk containing a large number of somatic cells and microorganisms were decanted into a separate container; Step 2—milk was decanted from each udder quarter according to the capacity of the test plate bowl; Step 3—the amount of milk was adjusted according to the line with the indicator of the milk level required for the study; Step 4—a portion of reagent (2 mL) was added to each bowl. Step 5—the reagent was mixed with milk by light circular movements of the containers. After a few seconds, interpretation was made according to the manufacturer’s recommendations; Step 6—the container was cleaned of the samples obtained. The obtained values were recorded for each animal. The status of the “healthy” or “subclinical mastitis” was confirmed in the animals by the district veterinarian.
PVC hoses used in the described milking systems were sent to the laboratory for pathogen growth studies. A low-quality rinsing was purposely performed for the study in order to evaluate the worst possible consequences of misuse of the milking systems.
All interaction with the animals was carried out by the farm staff. Milk transportation was carried out by the authors. The total time elapsed from the moment the milk was obtained until the start of the research to determine the accuracy of the light-scattering measuring module was no more than 4 h, and the experiment was conducted for 1 h.
2.2. Study of Pathogenic Microflora Growth Process in Milk Hoses of Milking System
The main material studied is PVC hoses. To ensure the correctness of the experiment, the same milk hoses were used on the laboratory bench as on the commercial farm that supplied us with milk for the study. This is a PVC 14 × 24 mm transparent milk hose made by Terraflex (Israel). It is safe for human health, has a high resistance to abrasion, high elasticity and resistance to shock load and a high resistance to vacuum, atmospheric, chemical and other influences.
The study required special equipment for growing pathogenic microflora, so we ordered work from a commercial laboratory to determine the total microbial count (TMC) and Staphylococcus count. The terms of reference for the laboratory consisted of 2 tasks:
To determine the number of bacterial colonies (TMC) and the number of Staphylococcus (aureus and epidermidis) from the total TMC by taking surface samples (samples were taken by swabbing), the stages of preparation, fixation and Gram staining of the smear were performed in accordance with the methodological recommendations for the organization of industrial microbiological control at dairy industry enterprises [21,22]. Microbiological control was carried out in a commercial laboratory. We took residual liquid samples from the PVC hose 6 h after warm water rinsing at 70 °C for 200 s under the condition of incomplete drying and residual milk in milking hoses after milking a healthy animal.
To determine the number of bacterial colonies (TMC) and the number of Staphylococcus (aureus and epidermidis) from the total TMC by taking surface samples (samples were taken by swabbing), the stages of preparation, fixation and Gram staining of the smear were performed in accordance with the methodological recommendations for the organization of industrial microbiological control at dairy industry enterprises [21,22]. Microbiological control was carried out in a commercial laboratory. We took residual liquid samples from the PVC hose 6 h after warm water rinsing at 70 °C for 200 s under the condition of incomplete drying and residual milk in milking hoses after milking an animal with mastitis (subclinical form).
Upon completion of the research, the commercial laboratory issued a protocol. The studies were conducted in accordance with the Russian standards GOST 30347-2016 (milk and dairy products) and GOST 32901-2014 (milk and dairy products; methods of microbiological analysis), as well as methodological recommendations for the organization of industrial microbiological control at dairy enterprises MR 2.3.2.2327-08 [21,23,24].
2.3. Simulation Modeling of Flow in Milk Hoses of Milking System and the Measuring Chamber of Light-Scattering Sensor
The research team developed a simplified model of a milking system, containing teat cups and a collector, a light-scattering sensor, a milk meter and a milk line connected by milk hoses. Using this model, we tested whether the temperature in the milk hoses of the milking system reached a temperature sufficient to kill pathogenic microflora (including Staphylococcus).
Modeling was carried out in the software product Solidworks 2021, in the Flow Simulation package. The following conditions were set for simulation modeling: the type of problem—internal; heat conduction in solids was selected; a non-stationary type of problem was set, where the study was conducted for 120 s with a step of 1 s; gravity along the Y axis was set equal to 9.81 m/s2, as a fluid flowing through the milking system in the process of flushing, and water was selected. The materials are: teat cups—stainless steel, silicon; collector—stainless steel, organic glass; PVC hoses with inner diameter 15 mm, outer diameter 22 mm. The tray milk meter was manufactured from the following materials: organic glass, stainless steel and plastic. For each material density, the specific heat capacity, conductivity type, thermal conductivity coefficient and melting temperature were set. The total volume flow rate of liquid at four teat cups was set to 0.0001 m3/s. At the outlet of the milk pipe, the boundary condition “static pressure” with thermodynamic parameters “temperature 20.05 °C, static pressure 44,000 Pa” was set. The global grid was set at 6 units. The solid body temperature and fluid medium temperature are set as targets.
A more detailed model of the measuring chamber of the light-scattering sensor was also developed. Figure 1 (where 1—case, 2–3—connections, 4—window for a laser beam, 5—pipe) shows the light-scattering sensor (Figure 1a), the measuring chamber of the device (Figure 1b) through which the milk–air mixture flows and a 3D model of the inner tube of the light-scattering sensor (Figure 1c). Figure 1c shows 3 lines—these are the lines, on which the graphs of the vortices and flow velocity of the flowing liquid are plotted.
Figure 1.
Light-scattering sensor and 3D model of the measuring chamber of the sensor for simulating milk flow: (a) light-scattering sensor; (b) measuring chamber of the sensor; (c) 3D model of the inner tube of the light-scattering sensor.
In the light-scattering sensor, the measuring chamber is made of engineering plastic polycarbonate; it has a window for the laser beam; the window is made of quartz glass.
The flow simulation was analyzed at two time intervals: 0.7 s and 2 s. These time intervals were taken for the reason that at 0.7 s the maximum flow intensity is reached and the hose is filled with milk, with the milk–air mixture consists 2/3 of milk and 1/3 of air. At 2 s, the flow intensity decreases until the hose is filled with the milk–air mixture with a 1/3 milk fraction and a 2/3 air fraction.
2.4. Accuracy Tests of the Light-Scattering Sensor and Processing of the Results
The test bench is a typical Herring-bone milking system, reduced to the laboratory size of 1 × 3 places. The technical characteristics of the test bench fully correspond to the milking systems used in animal farms (ISO 5707-83) [25]. Instead of an animal, the test bench uses an anatomically accurate udder model, to which the teat cups are connected.
Images of the test bench with the installation of elements and their description are presented in Figure 2. The test bench is shown schematically in Figure 2a; a cross-sectional side view (perspective) of the light-scattering sensor is depicted in Figure 2b.
Figure 2.
(a) Diagram of the milking line, (b) schematic diagram of the light-scattering sensor, (c) manufactured test bench: (1) teat cups; (2) milk collector; (3) PVC hose; (4) light-scattering sensor (4.1) case; (4.2) controller board; (4.3) silicone photodiode; (4.4) semiconductor laser; (4.5) measuring chamber; (4.6) laser scattered beam; (4.7) milk; (5) tray milk counter; (6) milk pipe.
The operation principle of the inline light-scattering sensor was described in the study [26]. Figure 2c shows the installation scheme of the light-scattering sensor in an operating milking unit.
The study of the accuracy of the light-scattering sensor consists of 2 stages (measurements with clean and contaminated milk hoses), repeated twice with milk of different fat content to ensure the high accuracy of the results.
First, 30 measurements of the percentage fat content of the milk were taken with clean milk hoses, and before and after the measurements these parameters were checked and compared using a reference method of milk quality analysis. Milk hoses and milking equipment were rinsed with warm water only. Then, after 4 h, 30 measurements of the milk fat content were taken again. The cycle was repeated for milk of 3.83% and 4.31% fat content. The somatic cell count is lower than 100 thousand/mL.
When assessing the statistical significance of differences in measurements, the hypothesis H0 assumes that the excessive contamination of milk hoses has no significant effect on the accuracy of the light-scattering sensor. The alternative hypothesis H1 suggests that contamination factors have an effect on the accuracy of the light-scattering sensor.
The data are tested for normal distribution according to the Shapiro–Wilk test. p < 0.05 is chosen as the level of significance. Comparison of these repetitions with the evaluation of significance by Student’s t-criterion should prove or disprove the influence of contamination in milk hoses of the milking unit on the effect of light scattering in milk and, accordingly, on the accuracy of the light-scattering sensor operation.
3. Results and Discussion
3.1. Study of Pathogenic Microflora Growth Process in Milk Hoses
Milk was transported from the farm to the laboratory, where it was tested for total microbial count and Staphylococcus count within 2.5 h.
Figure 3a,b show a raw milk sample from a healthy animal and a milk sample from a cow treated for mastitis. Figure 1c shows a Gram staphylococcal smear microscopy.
Figure 3.
Staphylococcus aureus growth on selective medium: (a) sample on raw milk; (b) sample on milk from a cow treated for mastitis; (c) Gram smear microscopy on sample b.
According to the research results, it was found that the total microbial count in raw milk was within the specified limits (1.2 × 104 CFU/mL), but the number of staphylococci was exceeded by 1.4 × 103 CFU/mL. This indicates that in the case of low-quality rinsing of milking hoses, bacterial growth occurs on residual milk and in hard-to-reach places of the milking system, which reduces the quality of the output product. When examining milk obtained from cows treated for mastitis (with the high somatic cell count (SCC)) with antibiotics (their list is not specified by farm workers), the total microbial count is higher than in raw milk and is 9.2 × 104, but the number of staphylococci is multiple times lower—5.0 × 101 CFU/mL.
The presence of pathogenic microbacteria even in the milk of healthy animals confirms the need for sanitary treatment of milking equipment. Contamination of milk with pathogenic microorganisms could be caused both by the violation of hygienic treatment of udders as described in [6] and the possible adhesion of pathogen colonies on stainless steel, rubber and plastic as described in [16].
Details of the results are presented in Table 1.
Table 1.
Results of a study of pathogenic microflora growth in milk hoses.
3.2. Simulation Modeling of Milk Flow in of the Milk Hoses and Measuring Chamber of the Light-Scattering Sensor
The developed model of the milking system is shown in Figure 4.
Figure 4.
Results of modeling the temperature of the rinsing mixture at the milking system.
According to the simulation results, it was found that after 120 s of flushing, the temperature in the teat cups reached 79.35 °C, the temperature in the collector was 79.01 °C, the temperature before the light-scattering sensor was 78.73 °C and after the light-scattering sensor was 78.41 °C. The lowest liquid temperature recorded in the end section of the milk pipe was 20.06 °C. Since it is known that S. aureus and S. epidermidis die at a temperature of 70 °C in 10 min, the pathogenic microflora is definitely destroyed in all hoses of the milking system. Consequently, quality rinsing ensures staphylococci disinfection throughout the entire line from the teat cups to the milk line due to a flow temperature of 79.35 °C to 76.28 °C.
Figure 5 presents the pattern of milk flow in the light-scattering sensor. The interpretation of Lines 1, 2, 3 is described in Section 2.2.
Figure 5.
Simulation results of the milk–air mixture flow through the measuring chamber at different fillings.
In Figure 5, when simulating a flow with a volumetric flow rate of 6 L/min, at 0.7 s, a uniform velocity flow is observed throughout the tube, which is divided into three lines, where Line 1 has an average flow velocity of 1.7 m/s, Line 2 has an average flow velocity of 0.2 m/s and Line 3 has an average flow velocity of 0.4 m/s. It is observed that the flow slows down near the tube walls, where the roughness of the walls affects the slowdown. The roughness of the material walls has no effect in the measuring chamber and in the area of quartz glass installation. The highest flow swirls are observed in the measuring chamber, in proximity to Lines 2 and 3. The values in the 0.7 and 2 s plots have a weak correlation between increasing the directional flow velocity and decreasing swirls. The flow swirl plot at 2 s shows that when the milk–air mixture consists of 1/3 milk and 2/3 air, there are two active swirl regions—in the measuring chamber and at the tube outlet.
Laboratory studies proved that the flow rate up to 6 L/min inclusive does not affect the accuracy of measurement, because at this flow rate swirling flow and liquid accumulation in the measuring chamber lead to a decrease in flow rate to 0.131 m/s, which is an acceptable speed for the device operation. The conducted modeling proves the constructive efficiency and feasibility of manufacturing a measuring chamber with a chute to accumulate milk.
3.3. Accuracy Tests of the Light-Scattering Sensor
For 3.83% milk, the mean ± standard deviation for clean hoses was (3.85 ± 0.07)%, for contaminated hoses (3.87 ± 0.15)%. For 4.31% fat milk, the mean ± standard deviation for clean hoses was (4.34 ± 0.11)%, for contaminated hoses (4.36 ± 0.18)%. For both stages of the accuracy study, graphs were generated to allow a visual assessment of variations in the measurement accuracy. They are presented in Figure 6 and Figure 7. All graphs are arranged in general coordinates (milk fat percentage was checked with a reference device—Lactan 1–4 M).
Figure 6.
Light-scattering sensor accuracy tests with 3.83% milk.
Figure 7.
Light-scattering sensor accuracy tests with 4.31% milk.
The dashed lines indicate the milk fat content measured by the reference method and the visually detected boundary of the influence of water in the hoses. The first three measurements, which should be recognized as incorrect due to a significant deviation from the actual results, are clearly marked on the graphs. The spread of deviations from the actual results for the contaminated hoses was 0.5% fat for 3.83% fat milk and greater than 0.6% fat for 4.31% fat milk. This effect may be due to the accumulation of water in the milk hoses, as well as incomplete filling of the milk hoses with milk during the first seconds of milking system operation. The milking system capacity was 5 l/min for the whole duration of the experiment.
The mean values and standard deviation differed very little for clean and contaminated (low-quality rinsed and dried hoses). Student’s t-test was used to statistically assess the significance of differences between data sets. The study was carried out for two pairs of data sets—milk with a fat content of 3.83% with clean and contaminated hoses; milk with 4.31% fat content with clean and contaminated hoses. The study determined no significant difference between clean and contaminated hoses at p < 0.05. It was concluded that low-quality rinsing and drying affect the measurement results only at the very beginning (first three measurements or first ~40 s), then the flow of the milk–air mixture was correctly estimated.
4. Conclusions
The article summarizes the results of a comprehensive study of the influence of milking system operating conditions on the accuracy of the light-scattering sensor. Based on the results, the authors put forward several recommendations for ensuring optimal operating conditions for milking systems, including the integration of a light-scattering sensor into them. The presence of S. aureus and S. epidermidis was detected, but their number proved to be much less than the one that could interfere with the light-scattering sensor (1.5 × 103 was detected, while a concentration of 1 × 105 would have an impact). When even milk from healthy animals is a suitable environment for the growth of pathogenic microflora, it is necessary to wash the milk hoses at a temperature of at least 80 °C. Modeling the milk flow in the measuring chamber of the light-scattering sensor showed a stable flow without stagnation. This will ensure that the milk in the measuring chamber is refreshed in time to provide up-to-date measurements of milk quality parameters, and that the milk hoses are rinsed properly. The accuracy of the light-scattering sensor will be quite high if we exclude the values of the first ~40 s after the start of the milking system operation, since milk residues and the filling of the milk hoses significantly reduce the accuracy of the device performance. The study results confirm that the light-scattering sensors are resistant to such factors of the milking system operation as contamination by pathogenic microflora (S. aureus and S. epidermidis) and the low-quality rinsing of milk hoses.
Author Contributions
Conceptualization, A.R.K. and S.S.Y.; methodology, A.R.K., A.S.D., D.Y.P. and A.V.S.; software, S.S.Y. and M.E.A.; validation, A.Y.I., A.S.D. and D.Y.P.; formal analysis, D.Y.P. and S.V.G.; investigation, A.R.K., S.S.Y., A.V.S., M.E.A., D.N.I. and S.V.G.; resources, S.S.Y. and D.N.I.; data curation, A.R.K.; writing—original draft preparation, A.R.K. and S.S.Y.; writing—review and editing, A.V.S.; visualization, A.R.K. and S.S.Y.; supervision, A.Y.I., A.S.D. and S.V.G.; project administration, A.R.K. and D.Y.P.; funding acquisition, A.S.D. and D.Y.P. All authors have read and agreed to the published version of the manuscript.
Funding
This work was supported by a grant of the Ministry of Science and Higher Education of the Russian Federation for large scientific projects in priority areas of scientific and technological development (grant number 075-15-2020-774).
Institutional Review Board Statement
Not applicable.
Informed Consent Statement
Not applicable.
Data Availability Statement
All data from this study are included within this manuscript.
Conflicts of Interest
The authors declare no conflict of interest.
References
- Evangelista, C.; Basiricò, L.; Bernabucci, U. An Overview on the Use of Near Infrared Spectroscopy (NIRS) on Farms for the Management of Dairy Cows. Agriculture 2021, 11, 296. [Google Scholar] [CrossRef]
- Beć, K.B.; Grabska, J.; Huck, C.W. Near-Infrared Spectroscopy in Bio-Applications. Molecules 2020, 25, 2948. [Google Scholar] [CrossRef] [PubMed]
- Hu, Y.T.; Ting, Y.; Hu, J.Y.; Hsieh, S.C. Techniques and methods to study functional characteristics of emulsion systems. J. Food Drug Anal. 2017, 25, 16. [Google Scholar] [CrossRef] [PubMed]
- Katsumata, T.; Aizawa, H.; Komuro, S.; Ito, S.; Matsumoto, T. Quantitative analysis of fat and protein concentrations of milk based on fibre-optic evaluation of back scattering intensity. Int. Dairy J. 2020, 109, 104743. [Google Scholar] [CrossRef]
- Khosroshahi, M.E.; Patel, Y.; Woll-Morison, V. Non-destructive assessment of milk quality using pulsed UV photoacoustic, fluorescence and near FTIR spectroscopy. Laser Phys. Lett. 2022, 19, 075602. [Google Scholar] [CrossRef]
- Pankey, J.W. Premilking Udder Hygiene. J. Dairy Sci. 1989, 72, 1308–1312. [Google Scholar] [CrossRef] [PubMed]
- Zhang, J.; Wang, J.; Jin, J.; Li, X.; Zhang, H.; Shi, X.; Zhao, C. Prevalence, antibiotic resistance, and enterotoxin genes of Staphylococcus aureus isolated from milk and dairy products worldwide: A systematic review and meta-analysis. Food Res. Int. 2022, 162, 111969. [Google Scholar] [CrossRef] [PubMed]
- Dubey, K.K.; Raj, T.; Kumar, P. Chapter 10—Pathogenic microorganisms in milk: Their source, hazardous role and identification. In Advances in Dairy Microbial Products; Woodhead Publishing: Sawston, UK, 2022; pp. 145–161. [Google Scholar]
- Abril, A.G.; Villa, T.G.; Barros-Velázquez, J.; Cañas, B.; Sánchez-Pérez, A.; Calo-Mata, P.; Carrera, M. Staphylococcus aureus Exotoxins and Their Detection in the Dairy Industry and Mastitis. Toxins 2020, 12, 537. [Google Scholar] [CrossRef] [PubMed]
- Jamali, H.; Barkema, H.W.; Jacques, M.; Levallée-Bourget, E.; Malouin, F.; Saini, V.; Stryhn, H.; Dufour, S. Invited review: Incidence, risk factors, and effects on clinical mastitis reccurence in dairy cows. J. Dairy Sci. 2018, 101, 4729–4746. [Google Scholar] [CrossRef]
- Feyissa, N.; Alemu, T.; Jirata Birri, D.; Dessalegn, A. Isolation, identification, and determination of antibiogram characteristics of Staphylococcus aureus in cow milk and milk products (yoghurt and cheese) in West Showa Zone, Ethiopia. Int. Dairy J. 2023, 137, 105503. [Google Scholar] [CrossRef]
- Stevens, M.; Piepers, S.; De Vliegher, S. Mastitis prevention and control practices and mastitis treatment strategies associated with the consumption of (critically important) antimicrobials on dairy herds in Flanders, Belgium. J. Dairy Sci. 2016, 99, 2896–2903. [Google Scholar] [CrossRef]
- Krivonogova, A.S.; Donnik, I.M.; Isaeva, A.G.; Moiseeva, K.V. Methodology for compiling a microbial resistance passport for dairy farms. Agrar. Bull. Ural. 2020, 200, 42–47. [Google Scholar] [CrossRef]
- Kaouche-Adjlane, S. Evaluation of the Hygienic Quality of Raw Milk at Different Levels of the Dairy Chain. Int. J. Innov. Approaches Agric. Res. 2018, 2, 349–358. [Google Scholar] [CrossRef]
- Griffiths, M.W. The microbiological safety of raw milk. In Improving the Safety and Quality of Milk; Woodhead Publishing Series in Food Science, Technology and Nutrition; Woodhead Publishing: Sawston, UK, 2010; pp. 27–63. [Google Scholar] [CrossRef]
- Amel, A.M.; Farida, B.; Djamila, S. Anti-adherence potential of Enterococcus durans cells and its cell-free supernatant on plastic and stainless steel against foodborne pathogens. Folia Microbiol. 2015, 60, 357–363. [Google Scholar] [CrossRef] [PubMed]
- Hoy, W.A.; Rowlands, A. Wet storage methods for the treatment of milking machine clusters. J. Appl. Microbiol. 1948, 11, 40–52. [Google Scholar] [CrossRef]
- Weber, M.; Liedtke, J.; Plattes, S.; Lipski, A. Bacterial community composition of biofilms in milking machines of two dairy farms assessed by a combination of culture-dependent and –independent methods. PLoS ONE 2019, 14, e0222238. [Google Scholar] [CrossRef] [PubMed]
- Narbayeva, D.; Myrzabekov, Z.; Ibragimov, P. Innovative ways to get milk with high sanitary indices. Res. Rural Dev. 2015, 1, 183–188. [Google Scholar]
- Bekuma, A.; Galmessa, U. Review on Hygienic Milk Products Practice and Occurrence of Mastitis in Cow’s Milk. Agric. Res. Technol. Open Access J. 2018, 18, 556053. [Google Scholar] [CrossRef]
- Stroyinf. Available online: https://files.stroyinf.ru/Data2/1/4293801/4293801959.pdf (accessed on 11 October 2023).
- Scheib, S.; Leimbach, S.; Avramidis, G.; Bellmann, M.; Nitz, J.; Ochs, C.; Tellen, A.; Wente, N.; Zhang, Y.; Viöl, W.; et al. Intermediate Cluster Disinfection: Which Disinfection Solution Is Most Effective on Milking Liners? A Comparison of Microorganism Reduction on Liner Inner Surfaces Using Quantitative Swab Sampling Technique. Pathogens 2023, 12, 560. [Google Scholar] [CrossRef]
- GOST 30347-2016; Milk and Milk Products. Methods for Determination of Staphylococcus Aureus. Standartinform: Moscow, Russia, 2016.
- GOST 32901-2014; Milk and Milk Products. Methods of Microbiological Analysis. Standartinform: Moscow, Russia, 2016.
- GOST 28545-90 (ISO 5707-83); Milking Machine Installations. Construction and Performance. IPK IZDATEL’STVO STANDARTOV: Moscow, Russia, 1990.
- Shkirin, A.V.; Astashev, M.E.; Ignatenko, D.N.; Suyazov, N.V.; Vedunova, M.V.; Gudkov, S.V. Laser Scatterometric Device for Inline Measurement of Fat Percentage and the Concentration Level of Large-Scale Impurities in Milk. Appl. Sci. 2022, 12, 12517. [Google Scholar] [CrossRef]
Disclaimer/Publisher’s Note: The statements, opinions and data contained in all publications are solely those of the individual author(s) and contributor(s) and not of MDPI and/or the editor(s). MDPI and/or the editor(s) disclaim responsibility for any injury to people or property resulting from any ideas, methods, instructions or products referred to in the content. |
© 2023 by the authors. Licensee MDPI, Basel, Switzerland. This article is an open access article distributed under the terms and conditions of the Creative Commons Attribution (CC BY) license (https://creativecommons.org/licenses/by/4.0/).